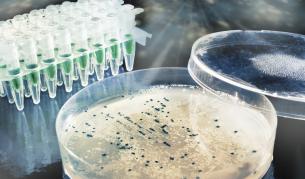
Най-голямото изчезване на видове е било заради микроби

Наука и техника
Най-голямото изчезване на видове е било заради микроби
01.04.2014
Досега учените считаха, че почти пълното унищожаване на живота в края на пермския период се е дължало на отделянето на въглеродни газове...

Какво ни очаква на Webit CEE Digital Summit тази година?
31.03.2014
Събитието ще се проведе на 9 април в Sofia Event Center, Paradise Mall

Сърцето на астронавтите е по-кръгло в Космоса
31.03.2014
Сърцето е с близо 10 на сто по-кръгла форма, когато е в безтегловност.

За 2 г. сме произвели 1139 професори и 1324 доценти
28.03.2014
Сигналите в МОН най-често съдържат данни за субективизъм при оценките в рецензиите и становища на членовете на журитата, че не са намерени...

Какво си казват прилепите, когато се спускат към плячка
28.03.2014
Мъжките прилепи издават звук, с който казват на конкуренцията "Махай се". Този звук не може да бъде чут от човешкото ухо

Космонавтите от "Союз" пристигнаха на борда на МКС
28.03.2014
Корабът, който бе изстрелян от Байконур в сряда, отведе до станцията в орбита руснаците Александър Скворцов и Олег Артемиев и американеца...

Двама британци се заразиха с туберкулоза от котка
27.03.2014
Двамата заразени с туберкулоза се възстановяват и рискът за по-нататъшно предаване на болестта от котки на хора е много нисък

Аутизмът се дължи на аномалии в мозъка на фетуса
27.03.2014
Откритието на американски невролози може да допринесе за по-ранно диагностициране на заболяването

За пръв път откриха пръстени около астероид
27.03.2014
"Цялото наблюдение на Харикло продължи пет секунди, но през това време успяхме да получим потресаващи снимки на пръстените", казват датски...

Как Даниел Киш "вижда" с ушите си
27.03.2014
Очите на Киш е трябвало да бъдат остранени заради рак, когато е бил още само на 13 месеца. Още като малък той се научил да издава звуци с...

Откриха нова малка планета в Слънчевата система
27.03.2014
Розовата смесица от буци лед и кръгли скали обикаля около слънцето на много по-голямо разстояние, отколкото който и да било друг извесен...

Гарваните са толкова умни, колкото е и 7-годишно дете
27.03.2014
Нови впечатляващи резултати от изследвания хвърлят светлина върху границите на познанията на гарваните

Български ученици спечелиха голямата награда на НАСА
25.03.2014
Със своите феноменални решения на проблеми, които и до днес затрудняват големите космически държави, нашите момчета се пребориха за...

НАСА откри обитаема планета извън Слънчевата система
25.03.2014
Астрономът Томас Баркли от Изследователския център на НАСА в Калифорния е направил откритието, използвайки данни, събрани от космическия...

Пускат на пазара първия 3D принтер за храна
25.03.2014
Вместо мастило, той използва капсули с различни хранителни съставки

Откритията на българка дават надежда за болни от рак
24.03.2014







